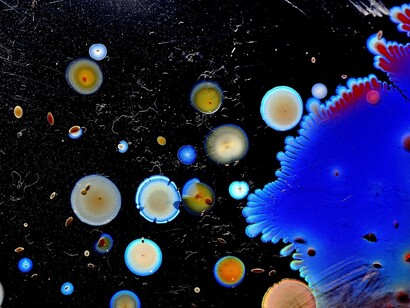
Batteri

“... La nostra società umana è simile ad una volta di pietre, che non cade proprio perché le pietre opponendosi l’una all’altra si sostengono a vicenda e quindi sostengono la volta”. Seneca afferma in questo modo come sia importante la diversità nel genere umano, perché crea una ricchezza e forza di coesione che rende stabile nel suo equilibrio la complessità del mondo. Ciò spiega anche l'innato desiderio dell'uomo di viaggiare attraverso il globo, alla ricerca di nuove conoscenze, di contatti con altre popolazioni per il semplice bisogno di arricchire quella curiosità verso il diverso o lo sconosciuto che completa e rafforza il concetto di uomo nella sua totalità. Come ci spiega Democrito, la paura dell'ignoto e il desiderio di conoscere sono le due forze uguali e contrarie che creano la tensione di colui che è saggio. “Ogni paese della terra è aperto all’uomo saggio: perché la patria dell’uomo virtuoso è l'intero universo”.
Ma l'apertura a nuove realtà, alle diverse popolazioni, ai differenti biotipi porta e ha portato a importanti conseguenze. Cioè ha esposto la popolazione mondiale al problema della migrazione delle patologie. "La conquista dell'America fu l'evento che implicò l'unificazione microbica del mondo" scrisse Giovanni Berlinguer alcuni anni fa in un editoriale su Immigrati e malattie. Pensiamo infatti alle stragi di indigeni americani provocate dall'arrivo di patogeni per i quali il loro sistema immunitario era privo di risposte, come il vaiolo, il morbillo e l'influenza. Così come dalle Americhe, spagnoli, francesi e italiani importarono invece quell'enorme e mortale problema infettivologico qual era la sifilide. Ugualmente nel XVII secolo, con la tratta degli schiavi neri prelevati dalle loro terre di origine africane, venne acquisita nelle Americhe la febbre gialla, non tanto per contagio umano, ma per importazione del vettore della malattia che era e che è la zanzara Aedes aegypti attraverso il trasporto dentro le navi e che là trovò un clima favorevole alla sua colonizzazione.
Si pensi alle epidemie di peste dal latino “peius” peggiore, considerata già nel Medioevo il male assoluto. La malattia era trasmessa dal topo nero, conosciuto come il topo delle navi, arrivava con i carichi marittimi nelle città di porto e si trasmetteva all'uomo con il morso delle pulci infettate dal batterio Yersinia pestis, parassita dei ratti. Recentemente un'altra grande epidemia ha coinvolto il mondo, l'AIDS, che è partita dagli Stati Uniti e si è diffusa a macchia d'olio grazie anche al metodo di diffusione per via sessuale che ha contribuito enormemente alla pandemia. Adesso il problema dei migranti che regolarmente sbarcano sulle coste italiane ha riacceso dubbi e timori di diffusione di malattie che in Italia e in Europa erano state debellate, come la tubercolosi che è aumentata di quasi il 50%: da 4 a 6mila casi all'anno la scabbia o addirittura le malattie mortali, come è emerso dal titolo di una delle circolari che il Ministero della Salute ha emesso in questi giorni Misure di sorveglianza per contrastare la diffusione dell'Ebola.
In realtà i massimi infettivologi italiani, che si riunirono per il X Congresso Nazionale della Società di Malattie Infettive e Tropicali, all'Arsenale Porto della Maddalena riferirono che questo allarme non esiste, gli immigrati arrivano stremati ma sani, tuttalpiù si ammalano qua e qua contraggono alcune malattie infettive a causa dello stress immunologico a cui è sottoposto il loro organismo a seguito dell'esperienza di migrante. E' quella che gli infettivologi definiscono “immunodepressione da sradicamento” e questa immunodepressione porta contrarre malattie e/o a riattivare patogeni silenti, contratti anni prima e che in condizioni fisiologiche normali non esprimono malattia.
David Murrell, ecologo dell'University College di Londra ha affermato che dal 1940 ad oggi, sono state identificate oltre 300 nuove malattie, il 60% delle quali frutto del passaggio da animale a uomo e il 70% del contatto tra essere umano e ambiente. Questo sta a significare che attraverso i mezzi di trasporto odierni, le infezioni si possono spostare attraverso i continenti in pochissime ore e che qualsiasi persona, dal vicino di aereo, alla persona che ci siede accanto nel tram, o che è accanto a noi in fila al supermercato, è un potenziale “untore”: si pensi che le goccioline di saliva che si diffondono con la tosse possono raggiungere 90 centimetri e con uno starnuto anche 3 metri. Questo non deve creare una psicosi di massa ma deve renderci consapevoli che il miglioramento delle condizioni igieniche, la maggiore diffusione delle vaccinazioni, l'attenzione nei rapporti sessuali e l'utilizzo di farmaci sempre più efficaci sono le nostre uniche armi a disposizione.